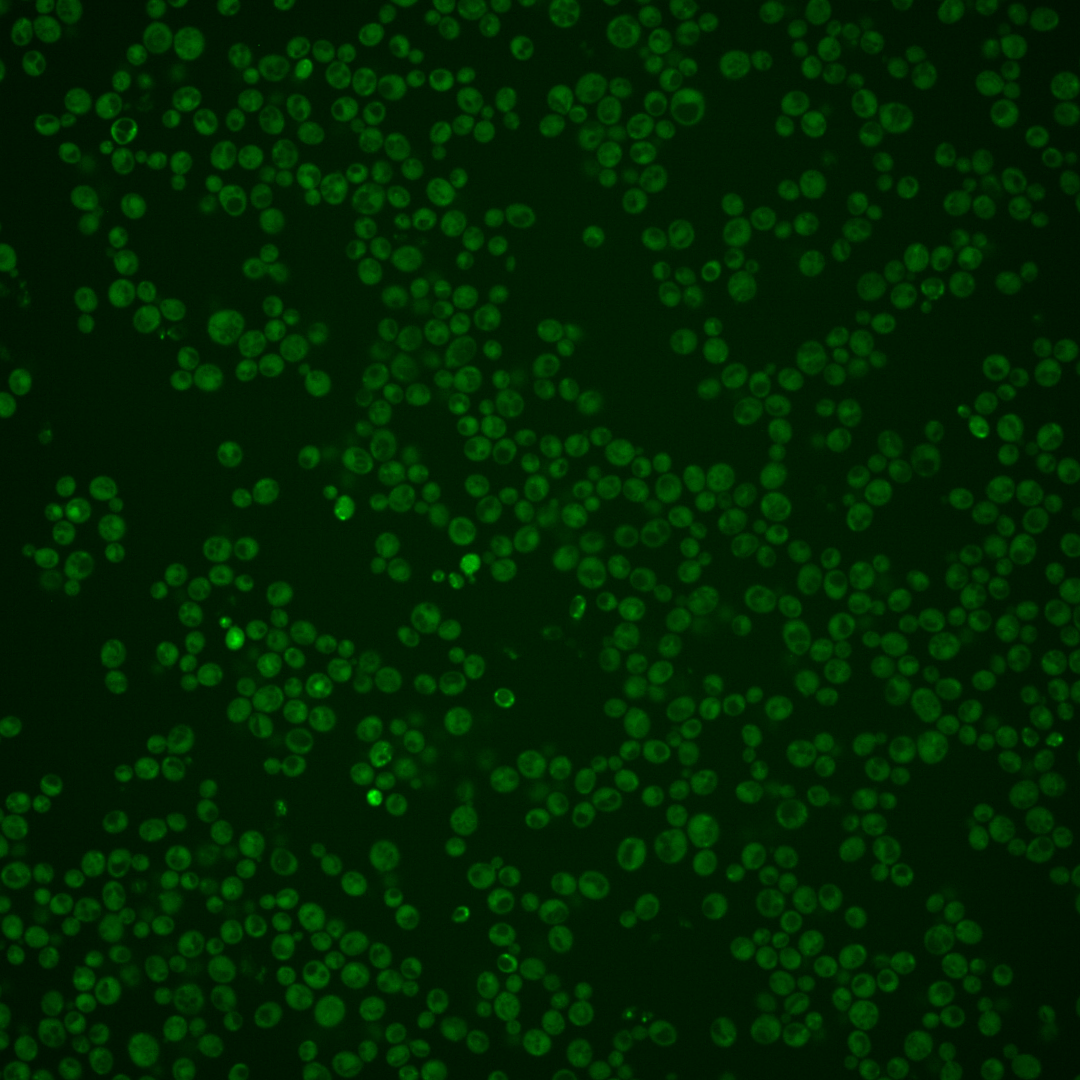
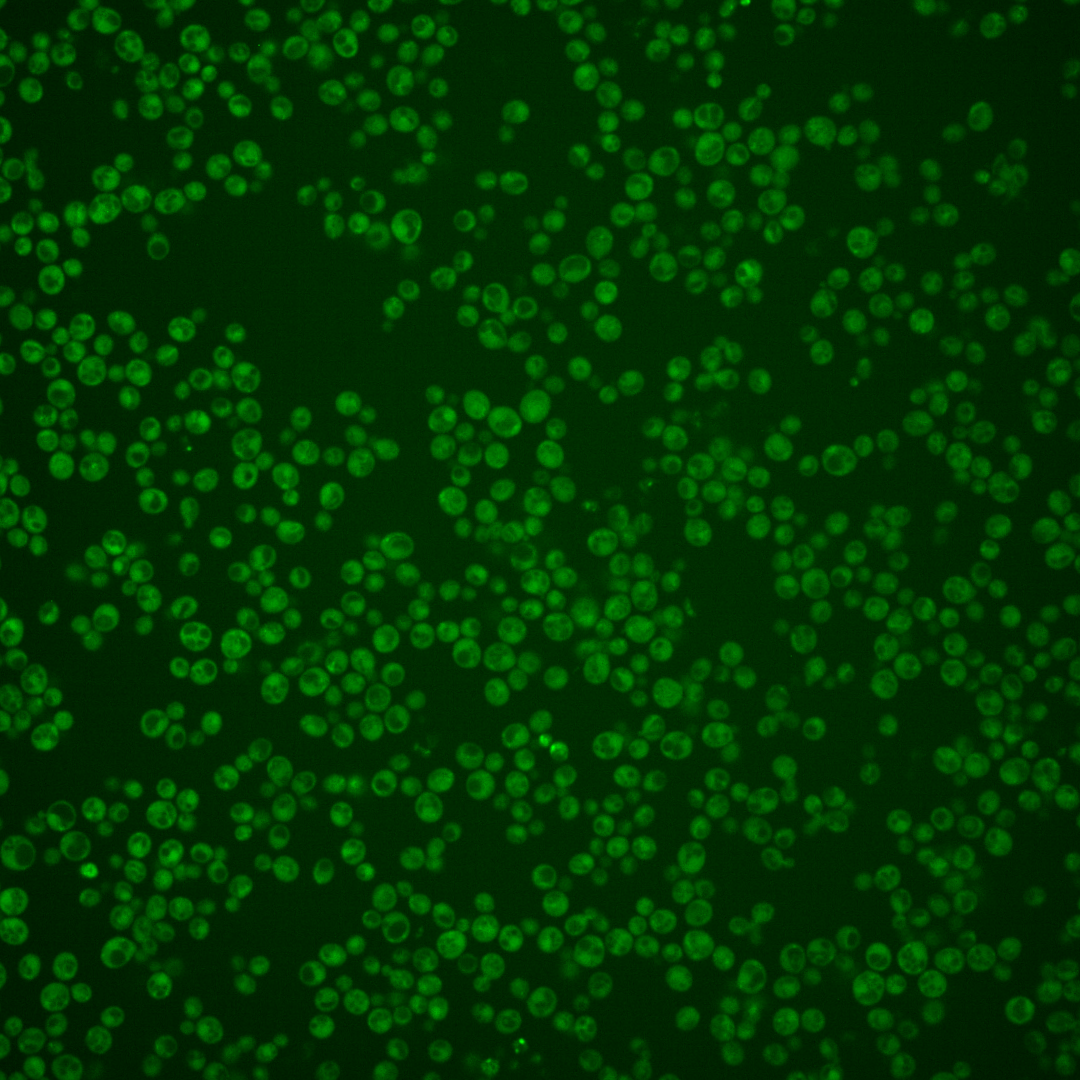
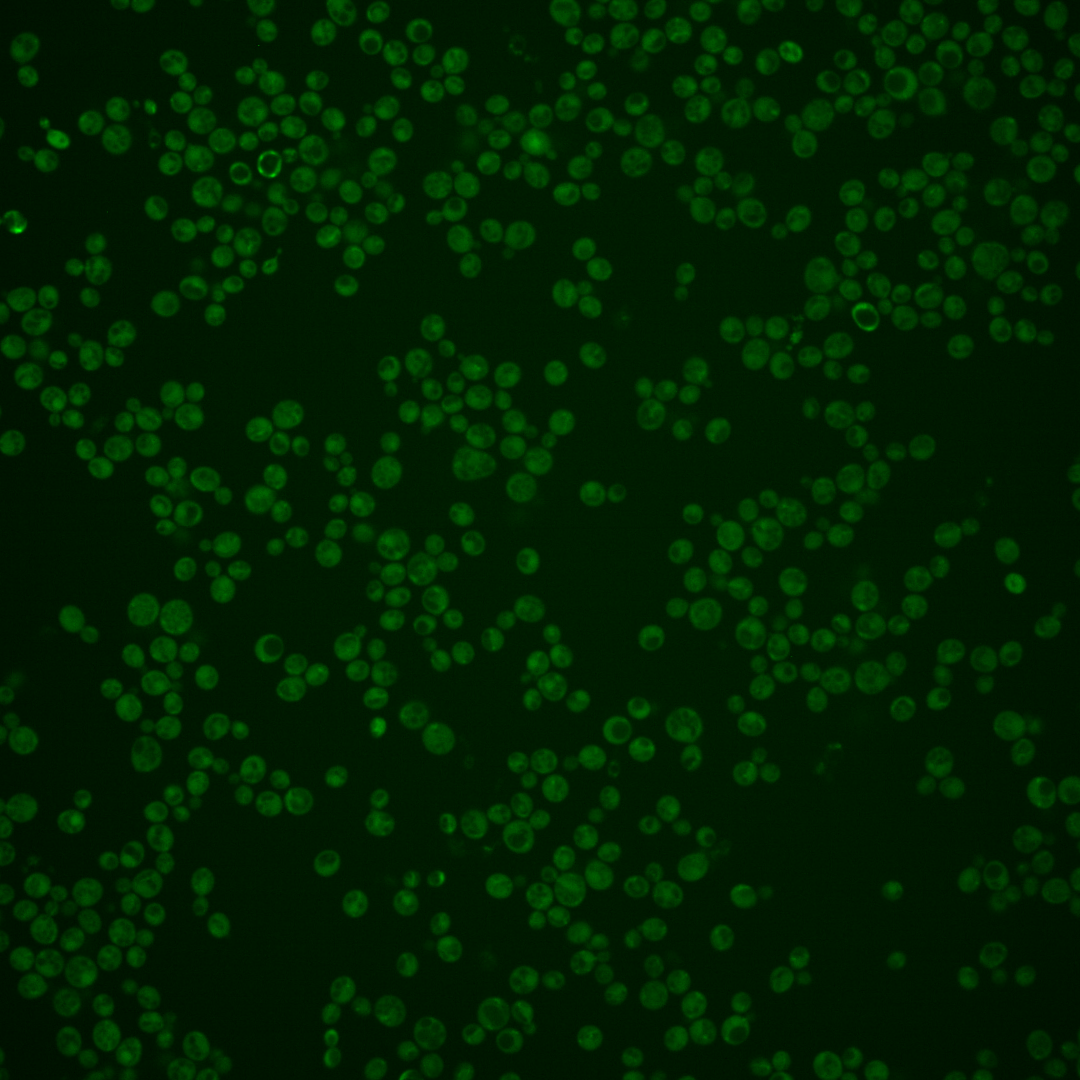
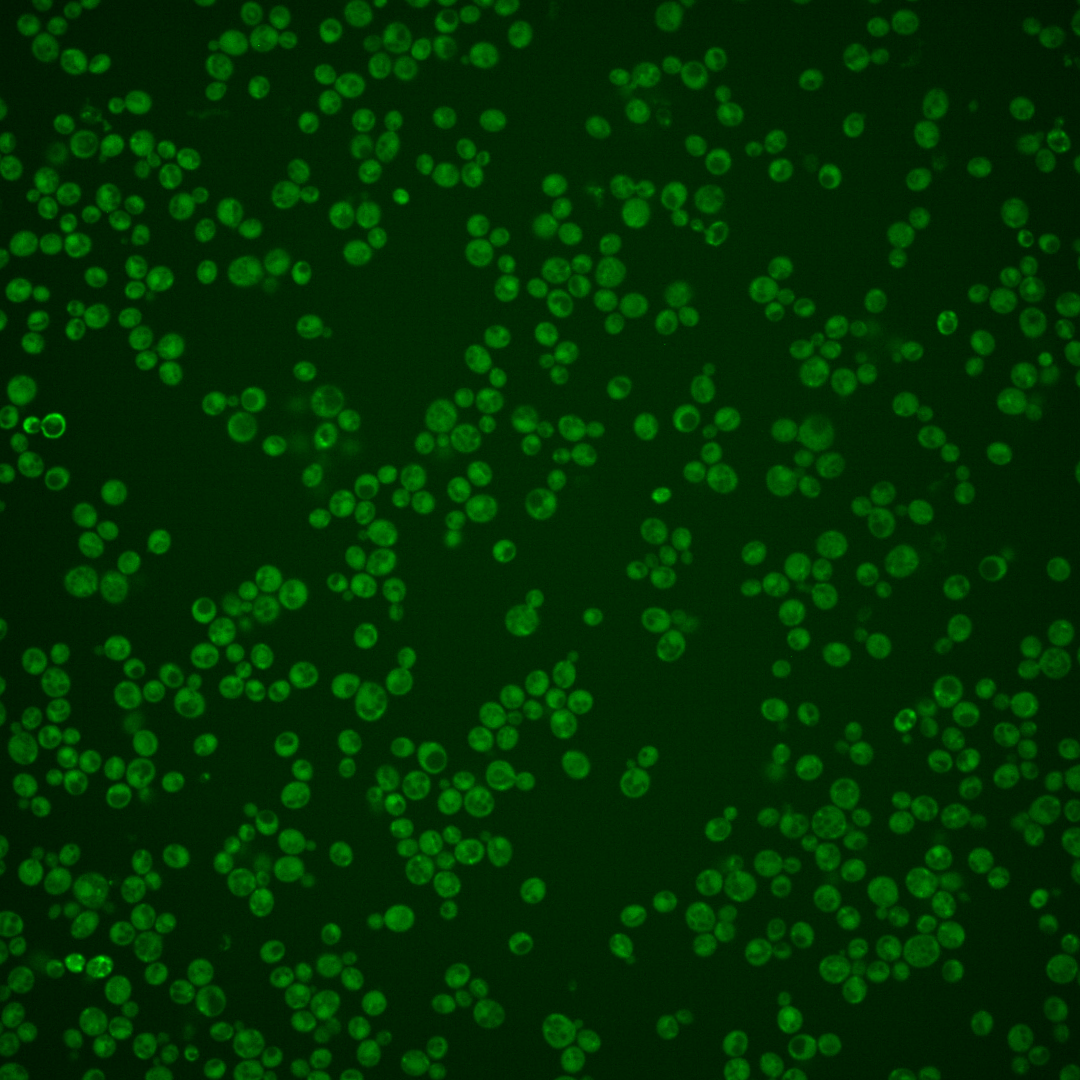

| ORF | |
|---|---|
| Human Ortholog | |
| Description | Putative protein of unknown function |
Micrographs




















































































Sub-cellular Localization
Yeast GFP Assignment
Protein Abundance
Localization Change
External localization resources
| ensLOC | DeepLoc | |||||||||||||||||||||||
|---|---|---|---|---|---|---|---|---|---|---|---|---|---|---|---|---|---|---|---|---|---|---|---|---|
| Localization | WT1 | WT2 | WT3 | RAP60 | RAP140 | RAP220 | RAP300 | RAP380 | RAP460 | RAP540 | RAP620 | RAP700 | HU80 | HU120 | HU160 | rpd3Δ_1 | rpd3Δ_2 | rpd3Δ_3 | WT1 | WT2 | WT3 | AF100 | AF140 | AF180 |
| Cortical Patches | 0 | 2 | 1 | 0 | 0 | 0 | 1 | – | 1 | 0 | 0 | 0 | 0 | 0 | 0 | 2 | 2 | 2 | 0 | 2 | 4 | 0 | 0 | 1 |
| Bud | 0 | 0 | 0 | 0 | 0 | 2 | 6 | – | 6 | 4 | 7 | 3 | 1 | 0 | 0 | 0 | 1 | 0 | 0 | 0 | 0 | 0 | 0 | 0 |
| Bud Neck | 0 | 0 | 2 | 0 | 1 | 1 | 4 | – | 0 | 3 | 0 | 1 | 0 | 2 | 0 | 0 | 1 | 0 | 1 | 1 | 2 | 0 | 1 | 1 |
| Bud Site | 0 | 0 | 0 | 0 | 0 | 0 | 0 | – | 1 | 1 | 1 | 1 | 0 | 0 | 0 | 0 | 0 | 0 | – | – | – | – | – | – |
| Cell Periphery | 0 | 0 | 2 | 0 | 0 | 0 | 3 | – | 1 | 3 | 0 | 0 | 0 | 0 | 0 | 4 | 4 | 1 | 0 | 0 | 0 | 0 | 0 | 0 |
| Cytoplasm | 80 | 44 | 75 | 161 | 234 | 178 | 226 | – | 123 | 133 | 151 | 147 | 37 | 74 | 107 | 198 | 193 | 177 | 40 | 44 | 36 | 13 | 34 | 81 |
| Endoplasmic Reticulum | 1 | 5 | 1 | 2 | 0 | 4 | 1 | – | 2 | 6 | 1 | 2 | 0 | 1 | 0 | 9 | 9 | 14 | 9 | 3 | 2 | 0 | 1 | 1 |
| Endosome | 0 | 1 | 0 | 2 | 10 | 24 | 30 | – | 16 | 21 | 12 | 27 | 0 | 0 | 1 | 16 | 17 | 22 | 8 | 8 | 2 | 0 | 0 | 1 |
| Golgi | 0 | 0 | 1 | 0 | 0 | 0 | 0 | – | 0 | 0 | 0 | 0 | 0 | 0 | 1 | 1 | 0 | 3 | 0 | 1 | 1 | 0 | 0 | 0 |
| Mitochondria | 7 | 5 | 0 | 2 | 3 | 13 | 38 | – | 60 | 44 | 100 | 80 | 3 | 0 | 0 | 6 | 4 | 7 | 44 | 30 | 40 | 4 | 6 | 13 |
| Nucleus | 0 | 0 | 0 | 0 | 0 | 0 | 6 | – | 4 | 0 | 4 | 4 | 1 | 0 | 0 | 2 | 3 | 0 | 0 | 0 | 0 | 0 | 0 | 0 |
| Nuclear Periphery | 0 | 0 | 0 | 0 | 0 | 0 | 0 | – | 0 | 0 | 0 | 1 | 0 | 0 | 0 | 0 | 0 | 0 | 0 | 0 | 0 | 0 | 0 | 0 |
| Nucleolus | 0 | 0 | 0 | 0 | 1 | 0 | 0 | – | 0 | 0 | 1 | 2 | 0 | 1 | 0 | 1 | 0 | 0 | 0 | 0 | 0 | 0 | 0 | 0 |
| Peroxisomes | 0 | 0 | 0 | 0 | 2 | 1 | 4 | – | 0 | 0 | 0 | 2 | 0 | 0 | 0 | 0 | 0 | 0 | 0 | 0 | 0 | 0 | 0 | 0 |
| SpindlePole | 0 | 0 | 0 | 2 | 4 | 3 | 8 | – | 11 | 5 | 2 | 13 | 0 | 0 | 0 | 4 | 3 | 0 | 1 | 1 | 0 | 0 | 0 | 0 |
| Vac/Vac Membrane | 0 | 3 | 1 | 5 | 17 | 29 | 31 | – | 22 | 22 | 25 | 24 | 0 | 0 | 0 | 22 | 39 | 40 | 20 | 17 | 14 | 3 | 7 | 14 |
| Unique Cell Count | 86 | 56 | 82 | 169 | 261 | 237 | 326 | 217 | 209 | 259 | 258 | 38 | 77 | 109 | 243 | 250 | 237 | 128 | 113 | 112 | 24 | 56 | 121 | |
| Labelled Cell Count | 88 | 60 | 83 | 174 | 272 | 255 | 358 | 247 | 242 | 304 | 307 | 42 | 78 | 109 | 265 | 276 | 266 | 128 | 113 | 112 | 24 | 56 | 121 | |
Yeast GFP Assignment
Protein Abundance
| Screen | WT1 | WT2 | WT3 | RAP60 | RAP140 | RAP220 | RAP300 | RAP380 | RAP460 | RAP540 | RAP620 | RAP700 | HU80 | HU120 | HU160 | rpd3Δ_1 | rpd3Δ_2 | rpd3Δ_3 | AF100 | AF140 | AF180 |
|---|---|---|---|---|---|---|---|---|---|---|---|---|---|---|---|---|---|---|---|---|---|
| Mean Cell GFP Intensity (1e-4) | 4.0 | 4.6 | 5.8 | 5.5 | 6.2 | 5.4 | 5.3 | – | 4.7 | 5.0 | 4.6 | 4.9 | 4.6 | 5.3 | 5.6 | 7.1 | 7.2 | 7.2 | – | 5.7 | 5.3 |
| Std Deviation (1e-4) | 0.4 | 1.0 | 1.0 | 1.6 | 1.9 | 2.5 | 1.5 | – | 1.4 | 1.4 | 1.1 | 1.1 | 0.5 | 0.9 | 1.7 | 1.3 | 1.3 | 1.6 | – | 1.8 | 1.1 |
| Intensity Change (Log2) | – | – | – | -0.07 | 0.11 | -0.09 | -0.13 | – | -0.29 | -0.2 | -0.34 | -0.25 | -0.34 | -0.12 | -0.05 | 0.31 | 0.32 | 0.31 | – | -0.02 | -0.11 |
Localization Change
| Localization | RAP60 | RAP140 | RAP220 | RAP300 | RAP380 | RAP460 | RAP540 | RAP620 | RAP700 | HU80 | HU120 | HU160 | rpd3Δ_1 | rpd3Δ_2 | rpd3Δ_3 |
|---|---|---|---|---|---|---|---|---|---|---|---|---|---|---|---|
| Actin | – | – | – | – | – | – | – | – | – | – | – | – | – | – | – |
| Bud | – | – | – | – | – | – | – | – | – | – | – | – | 0 | 0 | 0 |
| Bud Neck | – | – | – | – | – | – | – | – | – | – | – | – | 0 | 0 | 0 |
| Bud Site | – | – | – | – | – | – | – | – | – | – | – | – | 0 | 0 | 0 |
| Cell Periphery | – | – | – | – | – | – | – | – | – | – | – | – | 0 | 0 | 0 |
| Cyto | – | – | – | – | – | – | – | – | – | – | – | – | – | – | – |
| Endoplasmic Reticulum | – | – | – | – | – | – | – | – | – | – | – | – | 0 | 0 | 0 |
| Endosome | – | – | – | – | – | – | – | – | – | – | – | – | 0 | 0 | 0 |
| Golgi | – | – | – | – | – | – | – | – | – | – | – | – | 0 | 0 | 0 |
| Mitochondria | – | – | – | – | – | – | – | – | – | – | – | – | 0 | 0 | 0 |
| Nuclear Periphery | – | – | – | – | – | – | – | – | – | – | – | – | 0 | 0 | 0 |
| Nuc | – | – | – | – | – | – | – | – | – | – | – | – | – | – | – |
| Nucleolus | – | – | – | – | – | – | – | – | – | – | – | – | 0 | 0 | 0 |
| Peroxisomes | – | – | – | – | – | – | – | – | – | – | – | – | 0 | 0 | 0 |
| SpindlePole | – | – | – | – | – | – | – | – | – | – | – | – | 0 | 0 | 0 |
| Vac | – | – | – | – | – | – | – | – | – | – | – | – | – | – | – |
| Cortical Patches | – | – | – | – | – | – | – | – | – | – | – | – | 0 | 0 | 0 |
| Cytoplasm | – | – | – | – | – | – | – | – | – | – | – | – | 0 | 0 | 0 |
| Nucleus | – | – | – | – | – | – | – | – | – | – | – | – | 0 | 0 | 0 |
| Vacuole | – | – | – | – | – | – | – | – | – | – | – | – | 2.4 | 3.5 | 3.7 |
External localization resources
Images






























Protein Concentration and Protein Localization Data
| R1 | R2 | R3 | ||||||||||||||||
|---|---|---|---|---|---|---|---|---|---|---|---|---|---|---|---|---|---|---|
| G1 Pre-START | G1 Post-START | S/G2 | Metaphase | Anaphase | Telophase | G1 Pre-START | G1 Post-START | S/G2 | Metaphase | Anaphase | Telophase | G1 Pre-START | G1 Post-START | S/G2 | Metaphase | Anaphase | Telophase | |
| Concentration | – | – | – | – | – | – | – | – | – | – | – | – | – | – | – | – | – | – |
| Actin | – | – | – | – | – | – | 0.0907 | 0.0007 | 0.0017 | 0.011 | 0.0008 | 0.0078 | 0.0272 | 0.0002 | 0.0001 | 0.0001 | 0.0001 | 0.0009 |
| Bud | – | – | – | – | – | – | 0.0084 | 0.0044 | 0.0021 | 0.0005 | 0.0011 | 0 | 0.0009 | 0.0004 | 0.0008 | 0.0001 | 0 | 0.0001 |
| Bud Neck | – | – | – | – | – | – | 0.0016 | 0.0002 | 0.0009 | 0.0003 | 0.0121 | 0.0003 | 0.0061 | 0 | 0.0001 | 0 | 0.0085 | 0.0005 |
| Bud Periphery | – | – | – | – | – | – | 0.0125 | 0.0012 | 0.0049 | 0.0002 | 0.0014 | 0 | 0.0014 | 0.0001 | 0.0004 | 0.0002 | 0 | 0.0002 |
| Bud Site | – | – | – | – | – | – | 0.0057 | 0.0032 | 0.0102 | 0.0008 | 0.01 | 0.0001 | 0.0191 | 0.0005 | 0.0041 | 0 | 0.0001 | 0.0001 |
| Cell Periphery | – | – | – | – | – | – | 0.0037 | 0.0002 | 0.0001 | 0 | 0.0005 | 0 | 0.0006 | 0.0001 | 0.0001 | 0.0001 | 0 | 0 |
| Cytoplasm | – | – | – | – | – | – | 0.0542 | 0.0356 | 0.0319 | 0.0268 | 0.0234 | 0.0562 | 0.065 | 0.0823 | 0.0756 | 0.0847 | 0.1702 | 0.1223 |
| Cytoplasmic Foci | – | – | – | – | – | – | 0.0542 | 0.0047 | 0.0088 | 0.0159 | 0.0299 | 0.0092 | 0.0181 | 0.0055 | 0.0061 | 0.0016 | 0.0043 | 0.0067 |
| Eisosomes | – | – | – | – | – | – | 0.0012 | 0.0002 | 0.0001 | 0 | 0 | 0 | 0.0014 | 0.0001 | 0 | 0 | 0 | 0.0001 |
| Endoplasmic Reticulum | – | – | – | – | – | – | 0.0052 | 0.0008 | 0.0007 | 0.0003 | 0.0003 | 0.0003 | 0.0038 | 0.0003 | 0.0004 | 0.0029 | 0.001 | 0.0006 |
| Endosome | – | – | – | – | – | – | 0.0587 | 0.0037 | 0.0045 | 0.0113 | 0.0491 | 0.0036 | 0.0185 | 0.0009 | 0.0012 | 0.0012 | 0.0008 | 0.0065 |
| Golgi | – | – | – | – | – | – | 0.0231 | 0.0019 | 0.0008 | 0.0244 | 0.0188 | 0.0043 | 0.0052 | 0.0001 | 0 | 0 | 0 | 0.0003 |
| Lipid Particles | – | – | – | – | – | – | 0.0342 | 0.0012 | 0.0009 | 0.0001 | 0.0188 | 0.0004 | 0.0069 | 0.0002 | 0.0001 | 0 | 0 | 0.0005 |
| Mitochondria | – | – | – | – | – | – | 0.006 | 0.0008 | 0.0225 | 0.0052 | 0.002 | 0.0004 | 0.0035 | 0.0002 | 0.0002 | 0.0002 | 0.0001 | 0.0008 |
| None | – | – | – | – | – | – | 0.5387 | 0.9375 | 0.8994 | 0.9007 | 0.8097 | 0.9153 | 0.7809 | 0.9054 | 0.9075 | 0.9055 | 0.8128 | 0.855 |
| Nuclear Periphery | – | – | – | – | – | – | 0.0028 | 0.0002 | 0.0025 | 0.0001 | 0.0003 | 0.0001 | 0.0079 | 0.0003 | 0.0003 | 0.0003 | 0.0003 | 0.0011 |
| Nucleolus | – | – | – | – | – | – | 0.0003 | 0.0004 | 0.0007 | 0 | 0.0018 | 0 | 0.0037 | 0.0002 | 0.0001 | 0 | 0 | 0.0003 |
| Nucleus | – | – | – | – | – | – | 0.0026 | 0.0004 | 0.002 | 0.0001 | 0.0008 | 0.0001 | 0.0051 | 0.0011 | 0.0006 | 0.0003 | 0.0008 | 0.001 |
| Peroxisomes | – | – | – | – | – | – | 0.0864 | 0.0003 | 0.0013 | 0.0019 | 0.0057 | 0.0013 | 0.0154 | 0.0005 | 0.0001 | 0 | 0.0001 | 0.0002 |
| Punctate Nuclear | – | – | – | – | – | – | 0.0018 | 0.0004 | 0.0021 | 0.0001 | 0.0011 | 0.0002 | 0.0052 | 0.0012 | 0.001 | 0.0002 | 0.0003 | 0.0015 |
| Vacuole | – | – | – | – | – | – | 0.0069 | 0.0019 | 0.0014 | 0.0001 | 0.0113 | 0.0001 | 0.0029 | 0.0004 | 0.0008 | 0.0022 | 0.0003 | 0.0012 |
| Vacuole Periphery | – | – | – | – | – | – | 0.0012 | 0.0002 | 0.0005 | 0.0001 | 0.001 | 0 | 0.001 | 0.0001 | 0.0001 | 0.0003 | 0.0001 | 0.0004 |
Sequencing Data
| R1 | R2 | |||||||||
|---|---|---|---|---|---|---|---|---|---|---|
| G1 Post-START | S/G2 | Metaphase | Anaphase | Telophase | G1 Post-START | S/G2 | Metaphase | Anaphase | Telophase | |
| Gene Expression | 8.2963 | 7.4164 | 4.4026 | 9.615 | 7.171 | 14.925 | 5.1241 | 8.2665 | 8.542 | 12.3794 |
| Translational Efficiency | 1.0544 | 0.4906 | 0.6262 | 0.4791 | 0.9386 | 0.542 | 0.9403 | 0.4091 | 0.5068 | 0.5629 |
Hit Data
| Dataset | Hit |
|---|---|
| Protein Concentration | – |
| Protein Localization | ✘ |
| Gene Expression | ✘ |
| Translational Efficiency | ✘ |
Endocytosis
| Temp | Actin Patch (Sac6-tdTomato) | Cortical Patch (Sla1-GFP) | Late Endosome (Snf7-GFP) | Vacuole (Vph1-GFP) |
|---|---|---|---|---|
| 37℃ | ||||
| RT |
Cell Cycle Omics
CYCLoPs (Yml020w-GFP)
| Gene / Allele | Actin Patch (Sac6-tdTomato) | Cortical Patch (Sla1-GFP) | Late Endosome (Snf7-GFP) | Vacuole (Sac6-tdTomato) |
|---|
| Gene | Images |
|---|
| Gene | Images |
|---|
Images are not yet available
Images are not yet available